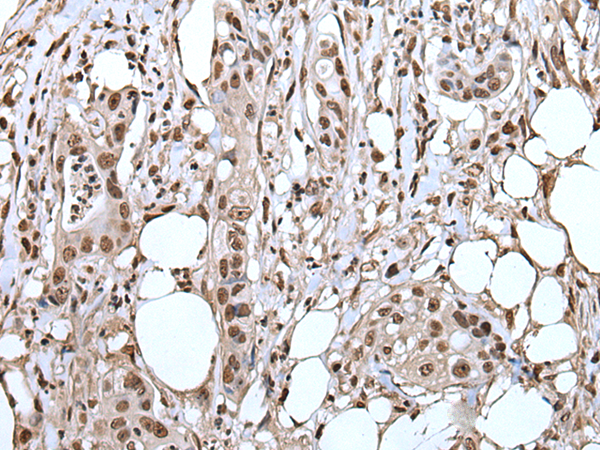
一抗

中文名稱: 兔抗ANP32A多克隆抗體
|
Background: |
Implicated in a number of cellular processes, including proliferation, differentiation, caspase-dependent and caspase-independent apoptosis, suppression of transformation (tumor suppressor), inhibition of protein phosphatase 2A, regulation of mRNA trafficking and stability in association with ELAVL1, and inhibition of acetyltransferases as part of the INHAT (inhibitor of histone acetyltransferases) complex. Plays a role in E4F1-mediated transcriptional repression. |
|
Applications: |
ELISA, IHC |
|
Name of antibody: |
ANP32A |
|
Immunogen: |
Full length fusion protein |
|
Full name: |
acidic nuclear phosphoprotein 32 family member A |
|
Synonyms: |
LANP; MAPM; PP32; HPPCn; PHAP1; PHAPI; I1PP2A; C15orf1 |
|
SwissProt: |
P39687 |
|
ELISA Recommended dilution: |
5000-10000 |
|
IHC positive control: |
Human colorectal cancer and human cervical cancer |
|
IHC Recommend dilution: |
25-100 |


 購物車
購物車 幫助
幫助
 021-54845833/15800441009
021-54845833/15800441009